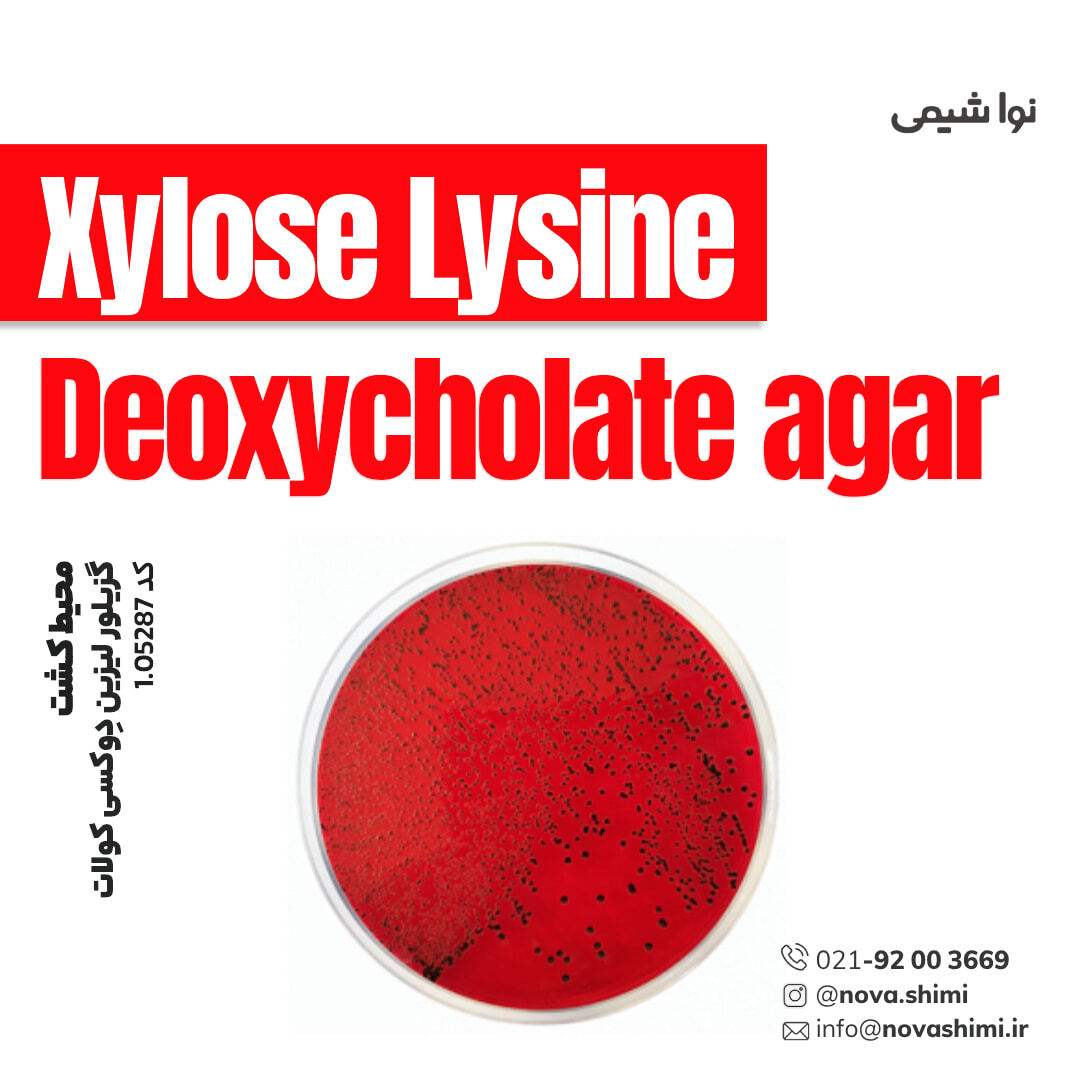
محیط کشت گزیلور لیزین دِوکسی کولات (XLD) (Xylose Lysine Deoxycholate agar)

محیط کشت گزیلور لیزین دِوکسی کولات (XLD) (Xylose Lysine Deoxycholate agar)
مشخصات فنی محیط کشت XLD:
1. برند: Merck Millipore
2. کاربرد: صنایع غذایی و نوشیدنیها، میکروبیولوژی
3. فرم فیزیکی: دانه ای(granular)
4. حجم بسته: 500 گرم
محیط کشت XLD چیست؟
محیط کشت گزیلوز لیزین دِوکسی کولات یک محیط انتخابی و افتراقی است که برای جداسازی، شناسایی و شمارش سالمونلا طراحی شده. شرکت نُـواشیمی، به عنوان یکی از تامین کنندگان مواد آزمایشگاهی و محیط کشت برند مرک و سیگما آلدریچ، آماده ارائه خدمات فروش محیط کشت XLD agar مرک کد 1.05287 به شما عزیزان خواهد بود. برای دریافت اطلاعات فنی و استعلام قیمت محیط کشت گزیلور لیزین دِوکسی کولات مرک، از طریق شماره 02192003669 با کارشناسان فروش نُـوا شیمی تماس حاصل فرمایید.
برای آشنایی بیشتر با ویژگیها و مشخصات محصول، میتوانید با کلیک روی هر عنوان، به توضیحات تکمیلی در زیرعنوانهای مربوطه دسترسی پیدا کنید.
مشخصات محصول (Product Specifications)
مشخصات فنی محیط کشت MSA مرک (Product Specifications)
در جدول زیر میتوانید مشخصات فنی محیط کشت گزیلور لیزین دِوکسی کولات مرک را مشاهده کنید.
عنوان | مشخصات فنی |
|---|---|
نام محصول | Xylose Lysine Deoxycholate Agar |
کد محصول مرک | 1.05287 |
شکل فیزیکی | پودر گرانوله با رنگ قرمز |
نوع محیط | انتخابی (Selective) و افتراقی (Differential) |
کاربرد اصلی | جداسازی و افتراق Salmonella spp. و Shigella spp. |
ترکیب پایه | زایلوز، لیزین، دئوکسی کولات، فنول رد، آگار |
pH در 25°C | 7.2 – 7.6 |
رنگ شاخص | فنول رد |
دمای انکوباسیون پیشنهادی | 37 ± 1°C |
ظاهر کلونی Salmonella spp. | مرکز سیاه (Black centre) |
ظاهر کلونی E. coli | زرد (تخمیر زایلوز) |
ظاهر کلونی سایر باکتریها | مهار یا رشد محدود |
شرایط نگهداری | 15–25°C، در محیط خشک و سربسته |
وزن بستهبندی استاندارد | 500 g |
مدت ماندگاری | 4–5 سال (در شرایط استاندارد) |
رطوبت مجاز | < 10% |
استاندارد سازنده | مطابق ISO 6579، ISO 19250، APHA، USDA-FSIS |
برای مشاهده اطلاعات کامل محصول در سایت مرک و جزئیات کاربردی آن، بر روی Xylose Lysine Deoxycholate agar کلیک کنید. شرکت نُـوا شیمی، تأمینکننده انواع محیط کشت برندهای معتبر مانند مرک و سیگما آلدریچ است و امکان خرید آسان و مطمئن این محصولات آزمایشگاهی را برای شما فراهم میکند.
آنالیز و کیفیت (Analysis Note)
ویژگیهای آنالیزی و کیفیت (Analysis Note)
Appearance (ظاهر فیزیکی): پودر یکنواخت، شفاف تا کمی کدر
Color (رنگ): قرمز
pH-value (25°C, 55 g/L in H₂O): 7.2 – 7.6
Form (فرم فیزیکی): پودر گرانولار قابل حل در آب
Growth Promotion Test (تست رشد میکروبی): مطابق DIN EN ISO 11133، بازیابی ≥50٪ برای Salmonella typhimurium و Salmonella enteritidis
Selectivity (انتخابپذیری): رشد باکتریهای ناخواسته محدود، رشد سالمونلا و شیگلا تشویق میشود
Colony Characteristics (ویژگی کلنیها): کلنیهای سالمونلا با مرکز سیاه، کلنیهای E. coli زرد
Application (کاربرد آزمایشگاهی): مناسب برای جداسازی و افتراق Enterobacteriaceae پاتوژن از غذا، آب و خوراک دام
Storage Condition (شرایط نگهداری): 15-25°C
جدول راهنمای ویژگیهای آنالیزی محیط کشت Xylose Lysine Deoxycholate agar
ویژگی | توضیحات | تحلیل و اهمیت |
|---|---|---|
Appearance (ظاهر فیزیکی) | پودر یکنواخت، شفاف تا کمی کدر | کیفیت بالا و ترکیب یکنواخت محیط را تضمین میکند |
Color (رنگ) | قرمز | شاخص pH قرمز-فنل برای افتراق تخمیر قندها در کلنیها |
pH (25°C, 55 g/L) | 7.2 – 7.6 | شرایط ایدهآل برای رشد سالمونلا و حفظ رنگ شاخص |
Form (فرم فیزیکی) | پودر گرانولار | سهولت در آمادهسازی محیط و کاهش ریسک آلودگی |
Growth Promotion Test | ≥50٪ بازیابی Salmonella spp. | تضمین کارایی محیط برای جداسازی سالمونلا |
Selectivity (انتخابپذیری) | محدود کردن رشد باکتریهای ناخواسته | افزایش دقت شناسایی سالمونلا و شیگلا |
Colony Characteristics | کلنیهای سالمونلا با مرکز سیاه | شناسایی بصری آسان و سریع باکتریهای هدف |
Application | جداسازی و افتراق Enterobacteriaceae پاتوژن | کاربرد در آزمایشهای کنترل کیفیت مواد غذایی و آب |
Storage Condition | 15-25°C | حفظ پایداری مواد محیط و جلوگیری از کاهش کیفیت |
خرید محیط کشت گزیلور لیزین دِوکسی کولات مرک (GranuCult® prime XLD agar)
خرید محیط کشت گزیلور لیزین دِوکسی کولات (XLD agar GranuCult® prime) کد 1.05287
محیط کشت Xylose Lysine Deoxycholate (XLD) آگار یک محیط انتخابی و افتراقی برای جداسازی و شناسایی احتمالی باکتریهای Salmonella spp. و Shigella spp. از نمونههای غذایی، خوراک دام و آب است. این محیط شامل قندهای زایلوز، لاکتوز و سوکروز به همراه شاخص pH فنولرد و ترکیبات سولفیت و آهن است که واکنشهای مختلف باکتریها مانند تولید اسید از قندها، تولید هیدروژن سولفید و دکربوکسیلاسیون لیزین را نشان میدهد و به شکل کلونیهای رنگی و سیاه در مرکز کلونیها قابل تشخیص است. آگار به عنوان ماده جامدکننده عمل میکند و محیط بهطور متوسط انتخابی است، بنابراین رشد میکروارگانیسمهای ناخواسته سرکوب میشود و باکتریهای هدف قابل افتراق هستند.
کمپانی مِرک (MERCK)
شرکت مرک (Merck KGaA) یکی از قدیمیترین و معتبرترین کمپانیهای علمی و فناوری در جهان است که در سال 1668 در آلمان تأسیس شد و امروزه بهعنوان پیشگام جهانی در حوزههای مواد شیمیایی آزمایشگاهی، بیوتکنولوژی و داروسازی شناخته میشود. بخش مواد آزمایشگاهی مرک، طیف گستردهای از مواد شیمیایی با گریدهای مختلف از جمله آنالیتیکال، ACS، HPLC، و Suprapur® را ارائه میدهد که برای تحقیقات علمی، کنترل کیفیت صنعتی، و مصارف آموزشی کاربرد دارند.
شرکت نُـوا شیمی، تامین کننده مواد آزمایشگاهی محیط کشت
شرکت نُـوا شیمی، با سابقهای درخشان در تامین مواد آزمایشگاهی، استاندارد ها و تجهیزات آزمایشگاه، با دسترسی گسترده به محصولات برندهای معتبر داخلی و بینالمللی، تامین نیازهای صنایع، آزمایشگاههای تحقیقاتی و داروسازی را با رویکردی مدرن و دقیق دنبال میکند. در صورت نیاز به استعلام قیمت محیط کشت گزیلور لیزین دِوکسی کولات مرک کد 1.05287 یا سایر مواد آزمایشگاهی، استاندارد و رفرنسهای آزمایشگاهی کارشناسان ما از طریق خط ویژه 02192003669 آماده پاسخگویی و ارائه مشاوره تخصصی به شما خواهند بود.
کاربردهای محیط کشت XLD
مهمترین کاربردهای محیط کشت XLD:
در ادامه، کاربردهای محیط کشت گزیلور لیزین دوکسی کولات مرک را مطالعه خواهیم نمود:
1. جداسازی و شناسایی Salmonella spp. و Shigella spp. از نمونههای غذایی و خوراک دام
XLD آگار یک محیط انتخابی و افتراقی است که به طور ویژه برای شناسایی احتمالی و جداسازی کلنیهای Salmonella و Shigella طراحی شده است. این محیط رشد باکتریهای موردنظر را تسهیل میکند و با نمایش کلنیهای سیاه (بر اثر تولید سولفید هیدروژن) یا کلنیهای زرد (بر اثر تخمیر زایلوز و سایر قندها) امکان تمایز سریع بین گونهها را فراهم میکند. این ویژگی آن را به ابزاری کلیدی در آزمایشگاههای کنترل کیفیت مواد غذایی و خوراک دام تبدیل کرده است.
2. کنترل کیفی آب و خوراک دام
XLD آگار قابلیت استفاده در بررسی نمونههای محیطی، آب و خوراک دام را دارد تا حضور انتروباکتریهای پاتوژن، بهویژه Salmonella و Shigella، شناسایی شود. با این محیط میتوان رشد میکروارگانیسمهای مزاحم را تا حدی مهار و تمرکز روی باکتریهای هدف را افزایش داد.
3. پژوهش و مطالعات میکروبیولوژی محیطی
این محیط در مطالعات میکروبیولوژیک و تحقیقاتی برای بررسی حضور و شیوع انتروباکتریهای بیماریزا در محیطهای مختلف استفاده میشود. امکان بررسی همزمان چند ویژگی متابولیک، از جمله تخمیر قندها، دکربوکسیلاسیون لیزین و تولید H₂S، باعث میشود دادههای دقیق و قابل اعتماد در مورد باکتریهای نمونه به دست آید.
4. آموزش و تمرینهای آزمایشگاهی
XLD آگار به دلیل قابلیت تفکیک واضح بین گونههای پاتوژن و غیرپاتوژن، در آموزشهای میکروبیولوژی کاربرد فراوان دارد. دانشجویان و محققان میتوانند با استفاده از این محیط، شیوههای جداسازی، شناسایی و تمایز باکتریهای گرم منفی انتروباکتریاسه را تمرین کنند و نتایج تجربی قابل مشاهده و تفسیر ارائه دهند.
5. کنترل فرآیند و آزمایشهای کنترل کیفیت صنعتی
در صنایع غذایی و دارویی، XLD آگار به عنوان ابزار کنترل فرآیند و تضمین ایمنی محصول مورد استفاده قرار میگیرد. با بررسی نمونههای تولیدی، این محیط امکان تشخیص سریع ورود Salmonella یا Shigella به محصول و اقدام به موقع برای اصلاح فرآیند تولید را فراهم میکند.
برای دریافت استعلام قیمت محیط کشت گزیلور لیزین دِوکسی کولات مرک کد 1.05287، لطفا با شماره 02192003669 تماس حاصل فرمایید. کارشناسان ما آماده پاسخگویی به سوالات شما هستند.
نکات ایمنی
نکات ایمنی و نگهداری (Safety & Storage)
در ادامه نکات ایمنی استفاده از محیط کشت گزیلور لیزین دِوکسی کولات مرک (Xylose Lysine Deoxycholate agar GranuCult® prime) برند مرک را مطالعه خواهیم نمود:
عنوان | مشخصات ایمنی |
|---|---|
کد کلاس نگهداری | 11 - مواد قابل اشتعال |
WGK | 3 |
نقطه اشتعال (°C/°F) | ندارد |
تجهیزات حفاظت فردی (PPE) | ماسک گرد و غبار نوع N95 (US)، محافظ چشم، دستکش |
دمای نگهداری توصیه شده | 15–25°C |
شرایط ایمنی کلی | از تماس مستقیم با پوست و چشم خودداری شود. در فضای تهویه مناسب استفاده شود. |
اگر به دنبال محیط کشت گزیلور لیزین دِوکسی کولات (XLD agar) هستید، نُـوا شیمی همراهی مطمئن در مسیر تامین نیاز های شما خواهد بود. برای سفارش، دریافت مشاوره فنی و آگاهی از شرایط همکاری؛ از طریق شماره 02192003669 با تیم فروش در ارتباط باشید.
سوالات متداول (FAQ)
سوالات متداول درباره محیط کشت XLD :
1. XLD آگار برای چه باکتریهایی مناسب است؟
مناسب برای جداسازی و شناسایی اولیه Salmonella spp. و Shigella spp. است.
2. آیا XLD آگار انتخابی یا غیرانتخابی است؟
این محیط به صورت انتخابی و افتراقی طراحی شده و رشد باکتریهای غیرهدف را مهار میکند.
3. دمای انکوباسیون توصیهشده برای XLD آگار چیست؟
دمای مناسب 37 ± 1°C به مدت 24 ± 3 ساعت است.
4. چه رنگی برای کلونیهای سالمونلا مشاهده میشود؟
کلونیهای Salmonella دارای مرکز سیاه به دلیل تولید سولفید هیدروژن هستند.
5. آیا XLD آگار برای نمونههای غذایی و محیط زیست کاربرد دارد؟
بله، برای نمونههای غذایی، خوراک دام، آب و سایر محیطها قابل استفاده است.
6. pH مناسب محلول XLD آگار در زمان استفاده چقدر است؟
pH بین 7.2 تا 7.6 در دمای 25°C، پس از حل کردن در آب.
7. آیا این محیط برای باکتریهای غیرانتروباکتریاسه قابل رشد است؟
رشد سایر باکتریها محدود یا مهار شده است؛ مانند Enterococcus faecalis که تحت تأثیر مهار کامل قرار دارد.
8. آیا میتوان از این محیط برای تست کیفیت آب و مواد غذایی استفاده کرد؟
بله، محیط XLD برای کنترل میکروبی و ایمنی غذایی و محیطی مناسب است.

هنوز نظری ثبت نشده
اولین نفری باشید که نظر میدهید
ثبت نظر